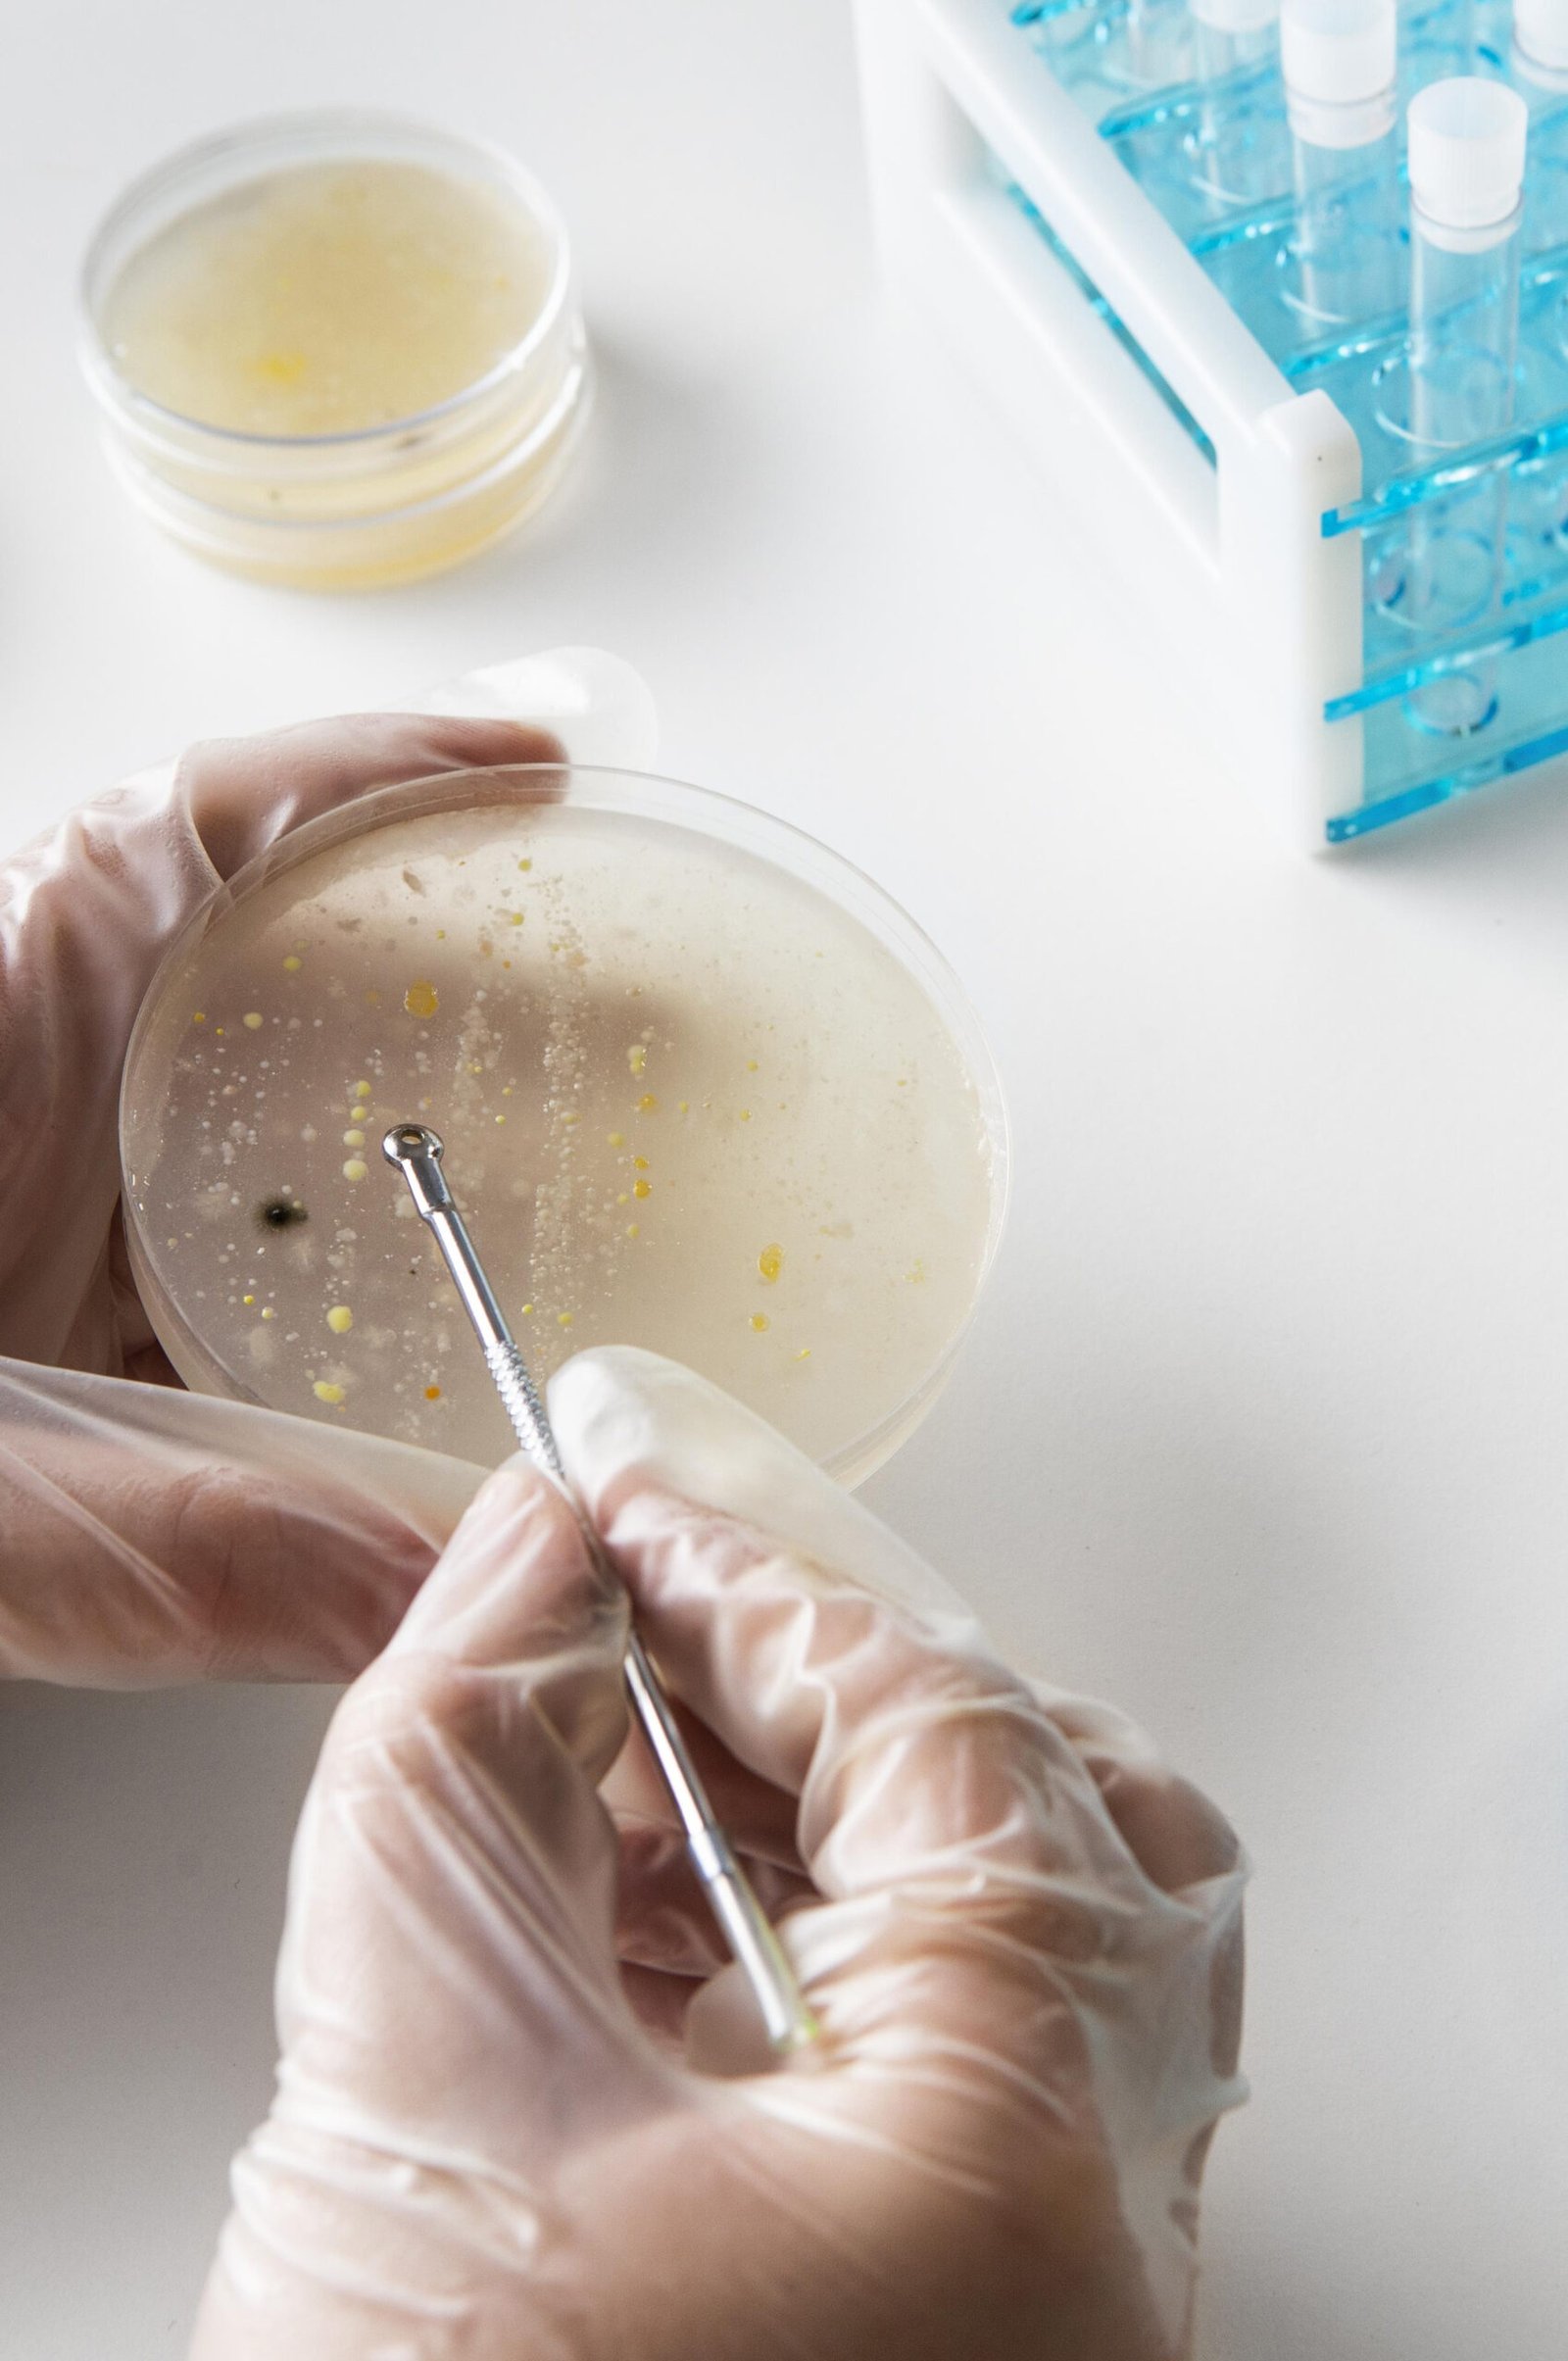

Brindar un servicio óptimo, eficiente y seguro en la prevención, diagnóstico, pronóstico, tratamiento y seguimiento de la salud de nuestros pacientes con exactitud en los resultados y la mayor calidad en la atención.

Ser el laboratorio de análisis clínicos líder de la región, de preferencia por su confiabilidad, exactitud y atención humanizada de sus pacientes. De referencia por parte de los profesionales de la salud, reconocido por su modelo de gestión y respaldado por la Comunidad Bioquímica Argentina.

Un pilar en el desarrollo y crecimiento de nuestro laboratorio y todo su equipo. Actualmente acreditados por el MA4 de la Fundación Bioquímica Argentina.
Procedimientos de identificación de pacientes y muestras desde la etapa de procesamiento de información pre analítica hasta la entrega de sus resultados.
Óptimo procesamiento de muestras y en el menor tiempo de obtención de resultados con la mejor calidad. Con un sistema de gestión basado en la mejora continua.
Atención centrada en el paciente, con un trato humanizado para con nuestros pacientes y colaboradores. Instalaciones especialmente diseñadas para el confort y la seguridad.